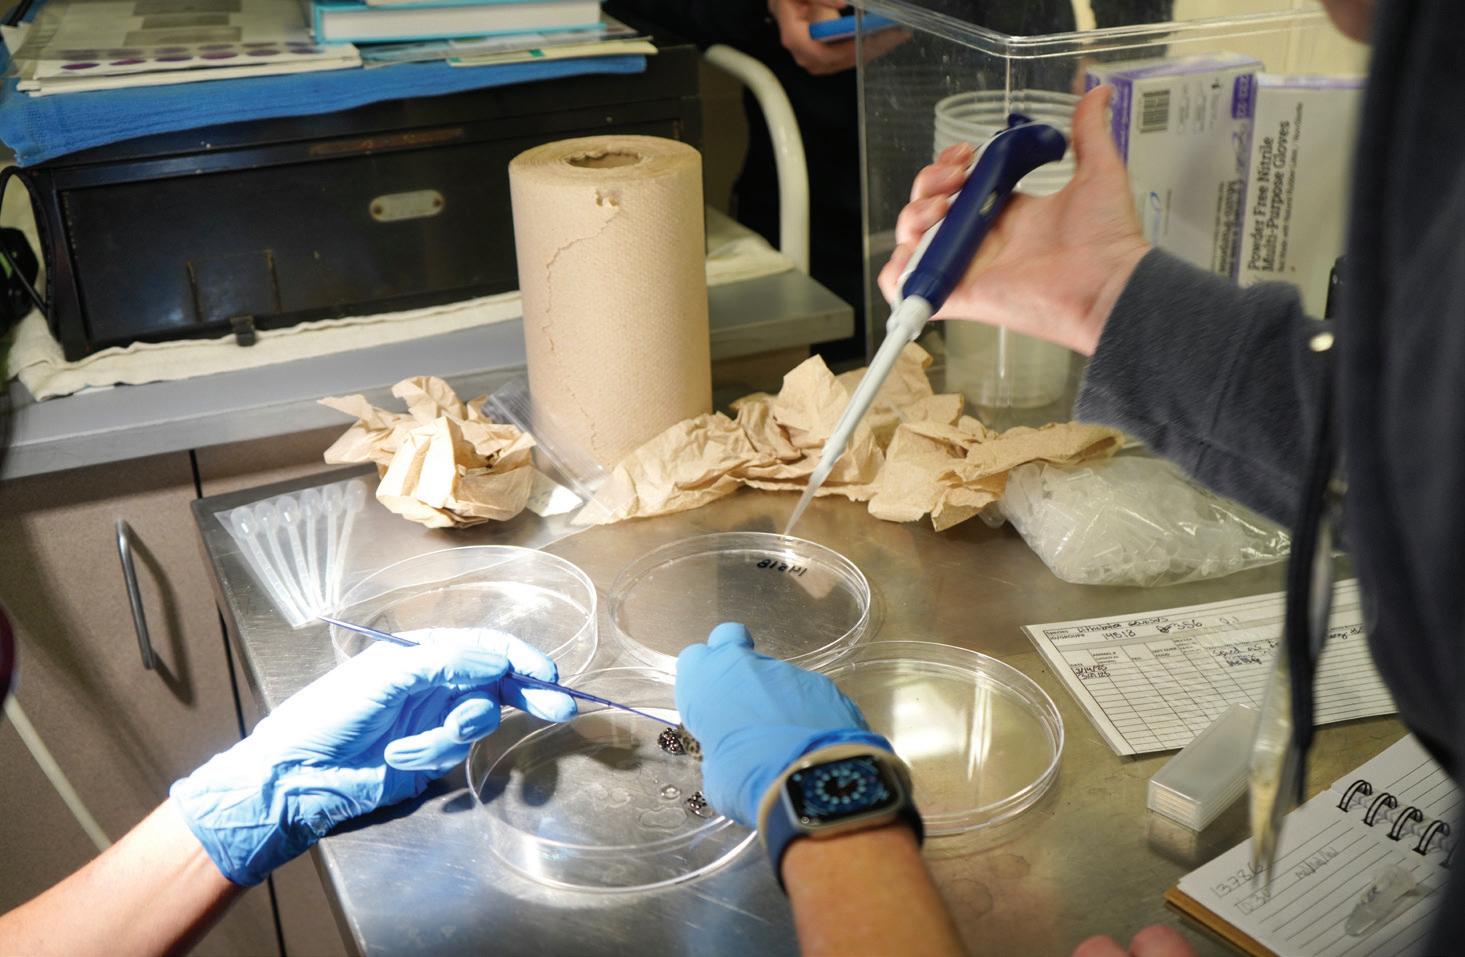

![]()





































You might not expect it, but winter is a truly magical time at the Detroit Zoo and Belle Isle Nature Center. There’s something special about wandering through the quieter paths and watching winterloving animals play in the snow. And when you’re ready to warm up, our indoor spaces — from the lush butterfly garden and Matilda R. Wilson Free-Flight Aviary to the National Amphibian Conservation Center and more — offer the perfect retreat.
In this edition of Habitat, you’ll discover why this season shines so brightly here. Explore our award-winning holiday light display, Wild Lights, meet some of the incredible team members who care for the animals year-round, and get a behind-the-scenes look at how our conservation experts are helping restore populations of critically endangered amphibians to their native homes.
None of this would be possible without supporters like you Your visits, enthusiasm and support power everything we do — animal care, global conservation, community engagement, education and environmental sustainability. As we look ahead to 2026, I hope you’ll make time for another adventure at the Zoo or Nature Center. Whether you’re wandering through an event like Wild Lights or enjoying a stroll through the Nature Center's trails, there’s always something new to discover. We can’t wait to share it with you.
Dr. Hayley Murphy











Mary Humbyrd is the behavioral husbandry coordinator for the Detroit Zoo. Through her work, she supports the animal care team in designing and implementing training and enrichment opportunities that support the animals’ well-being and natural behaviors.
What do you do at the Zoo?
The behavioral husbandry coordinator supports the zookeeper staff with training, enrichment, husbandry planning, brainstorming and problem solving. I help ensure the science of behavioral husbandry is distributed to staff so they have the most up-to-date information on how to best care for the animals.
What does an average day look like?
I like to say that I have the best job at the Zoo. I get to work with all different species, which has really broadened my horizons. I start my mornings with the zookeeper staff — and that can look like working with the giraffes on hoof training or going on a donkey walk or training with the elands to voluntarily participate in veterinary care. I then have many meetings around welfare assessments, training and enrichment, teaching classes, and working with staff on new enrichment. The rest of my day could be spent collecting data for the team and interpreting it to ensure that what we are doing is working and supporting animal well-being. The most fulfilling part of my day is supporting zookeeper staff and their passion for working with animals. It brings me absolute joy to be a part of that process.
How did you get into this line of work?
I was an animal person from a very young age. I’ve always wanted to be with and work with animals, and I have always been incredibly passionate about training and

“ I was an animal person from a very young age. I've always wanted to be with and work with animals, and I have always been incredibly passionate about training and enrichment.”
enrichment. I started at the Zoo 25 years ago as a zookeeper and moved into this new position a few years ago. Now, I’m getting to support training and enrichment on a whole new level, see the science
being brought in and support staff as they start their journey as I did so many years ago. It’s so fun and incredible to watch.
Do you have any advice for young people who want to work with animals?
My advice would be to keep an open mind about experiences that come your way, even if they aren’t exactly what you think you want. In the animal care field, your passion drives you — that can be given to any species in any location. Also, stick with it. It’s not always easy, but the peace that you get from having the honor and privilege of working with animals is a priceless gift.


By Karen Dybis, Contributing writer
Dusky gopher frogs are adorably winsome with big eyes, round stomachs and a call that sounds like a post-dinner snore—and they’re one of the rarest amphibians in the United States. Habitat loss, combined with pollutions and natural disasters have put the dusky gopher frog on the endangered species list since 2001.
“They’re a hearty species, but due to habitat loss and habitat degradation, they lack areas where they can go,” the Detroit Zoo’s Curator of Amphibians Mark Vassallo says. “Their habitat, longleaf pine forests, used to cover most of the Southeast United States. Now, due in part to habitat loss, there's not many of these amphibians left.”
But efforts happening behind the scenes at the Detroit Zoo are helping the dusky gopher frog’s survival. Since 2018, Vassallo, veterinarian and Associate Vice President of Life Sciences Dr. Ann Duncan and a Detroit Zoo team have joined zoos nationwide to set up strategies for the frog’s long-term success in the wild.
One of those efforts is assisted reproductive technology (ART), a breeding technique that has created hope among amphibian conservationists that the dusky gopher frog will continue to thrive in its native Mississippi, where it lives in ponds and longleaf pine forests.
(Continued on page 7)




(Continued from page 5)
“The dusky gopher frog is an indicator of our Earth’s overall health. Amphibians absorb what’s in our environment through their skin. They’re a watermark for a healthy ecological system,” Vassallo says.
Why is their survival a priority? The first reason is their help with eating pests and other unwanted insects in the agricultural ecosystem, Vassallo says. And the dusky gopher frog is part of the energy transfer that occurs between the aquatic and terrestrial worlds as they share burrows with the gopher tortoise and other small mammals. In other words, without them, there wouldn’t be enough for other populations to eat.
So, how do organizations like the Detroit Zoo come in? It’s all part of the frog’s Species Survival Plan, and the dusky gopher frog is top priority for Duncan, whose collaboration with program partners across the US has helped breed and release more than 10,700 of these amphibians back into their natural habitat through 2025.
Duncan, the head veterinarian for the DZS who oversees the Ruth Roby Glancy Animal Health Complex at the Detroit Zoo, says the ART process is simple yet complicated — believe it or not, she says there is a detailed book of how to do it, and she even took a class to learn the procedure. It takes a bit of practice, but once you know, you know, she adds.
It starts with an ultrasound on every possible breeding-age frog within the Zoo’s population. This first separates the male from the female frogs. For the females, Duncan says they look for follicle development, and then they grade each one for how mature the follicles are. Those who are the most mature are then up to bat.
In the most recent effort, Duncan says they selected 10 females and 10 males to serve as donors. All the volunteer amphibians are moved up to the Zoo’s breeding environment within its animal
hospital, where they are treated like celebrities. The Zoo staff treats the females with hormones and uses an ultrasound machine to look for follicular development and see if their eggs are ready to fertilize.
“You’re looking for something really subtle in those eggs, a kind of gelatinous exterior to the eggs. When you see it, you know they’re ready to be fertilized and it’s time to go for it,” Duncan says.
The female is gently tickled with a special tool, and she responds by laying eggs. Next, the males are prepared in a similar way — they receive hormone injections and are tickled to collect male reproductive cells. These cells are studied under a microscope to determine their health, and the best of the best are then cascaded over the female eggs.
The Zoo then steps back to let nature take over, Duncan says. Within a few minutes, the fertilized eggs are ready, and they get splashed with water — kind of like it might be if it were to rain in the wild, Duncan says. The next day, the Zoo
“The dusky gopher frog is an indicator of our Earth's overall health. Amphibians absorb what's in our environment through their skin. They're a watermark for a healthy ecological system.”
— Mark Vassallo, Detroit Zoo’s Curator of Amphibians

staff arrives at work with high hopes for a successful ART procedure, something you can see as the eggs start to develop.
To make sure everything is proceeding, Duncan says they will examine the eggs under a microscope once again, looking for that rapid-fire division of cells that means frog life has begun. Sometimes, the eggs fail to develop. But, miracle of miracles, the Detroit Zoo has experienced great results. And thanks to this great work, once the frogs hatch and grow, they are sent to partner facilities across the country before eventually being released into the wild, where they help us all take one big leap toward conservation.
“You can see their tails start to grow, and it is a miracle,” Duncan says. “It’s a huge effort that takes four to eight hours a day for a solid week, but it’s an amazing experience. ... I’ve always loved amphibians, and I’m so glad to contribute to their conservation.”

Holiday tradition returns to light up memories for another season
Wild Lights is back — and you won’t want to miss it!
Wild Lights, presented by Michigan First Credit Union, is a holiday light show, a nighttime stroll and a core family memory waiting to happen. More than 500 dazzling displays and millions of LED lights guide you through a trail filled with wonder, warmth, sound and surprise.
Whether it’s a bundled-up family outing, a cheerful date night, a gathering with friends or simply a moment to breathe in the beauty of winter, this event offers something meaningful for anyone who experiences it.
Plus, this year, we’re taking the holiday magic to the next level. Guests will be able to explore brand-new displays, including an enchanted rainforest, and

enjoy interactive light-up lanyards that dance to the sounds of the season. You can also enjoy delicious winter eats and sweets, get creative at the giant Light Bright and discover even more surprises along the way.
And don’t worry — your favorite traditions are back, too! Snap a photo with Santa, experience Rudolph the Red-Nosed Reindeer in 4D and revisit all the dazzling displays you’ve come to love year after year.
Don’t miss out on the chance to make a core memory — get your tickets today at dzoo.org/wildlights!
PRESENTED
BY

WILD LIGHTS SCHEDULE
December: 5-7, 11-23, 26-31
January: 2-4
Fridays and Saturdays: 5 to 10:30 p.m.
All other days: 5 to 9 p.m.



By Sarah Culton, Communications Manager
What happens when a gorilla gets a toothache? At the Detroit Zoo, it means a trip not to the neighborhood dentist, but to the Zoo’s Ruth Roby Glancy Animal Health Complex, where a team of veterinary specialists steps in to help.
That was the case for Mshindi, a silverback gorilla and resident of the Great Apes of Harambee habitat, who recently received specialized dental care to keep his teeth — and overall health — in top condition.
Just like it is for people, dental care is an essential component of preventive animal medicine, and the Zoo’s veterinary staff takes it seriously. Regular oral exams help ensure that animals like Mshindi maintain healthy teeth and gums, reducing the risk of infections and other health complications down the line.
“The animals in our care live a lot longer than they might in the wild, so maintaining good dental health is really important so they can break down food, digest it and get all the nutrition they need,” says Dr. Ann Duncan, associate vice president of life sciences for the Detroit Zoo.
The Zoo’s veterinary team takes a proactive approach to dental health, using exams, X-rays and CT scans to spot potential issues long before they become serious. Treatment can range from routine cleanings and polishings — sometimes performed several times a year — to more advanced procedures like root canals. The goal is simple but essential: keeping every animal’s mouth healthy, preventing buildup of calculus and treating problems early to ensure they’re free from more severe problems and discomfort.
Preventive care is especially important because many animals are skilled at hiding signs of dental pain. Subtle behaviors,
such as chewing on one side of the mouth or touching or rubbing the face, can be the only indicators of an issue. When Mshindi began showing possible signs of discomfort, the Zoo’s veterinary team called on a trusted partner for help.
That partner was Dr. Ben Colmery, a board-certified veterinary dentist and oral surgeon with more than 20 years of experience. While his day-to-day work focuses on domestic pets, Colmery has long collaborated with the Zoo, helping care for species ranging from aardvarks to river otters — one of whom still sports a gold tooth implanted by Colmery.
“I really enjoy working with the Zoo,” Colmery says. “They do a superb job caring for the animals, so when I’m brought in, it’s just to provide a bit of extra support and expertise. I find it rewarding to work with animals most people never get the chance to see outside of their habitats.”
When Colmery joined Mshindi’s case, the team placed the silverback under anesthesia to conduct a thorough oral exam. Their investigation revealed a defect between two molars that had led to bone loss from trapped food. To resolve the issue, the team decided they needed to remove the affected tooth. In a second area, they found abnormal wear to a tooth from abnormal tooth alignment. To avoid future issues, Dr. Colmery applied a protective barrier coating to the tooth.
Today, Mshindi is eating better and seems to have better oral comfort. Duncan says she is proud of her entire team for their work on his case and that it is just one example of many of the ways the Zoo team ensures the animals in their care are thriving.
“Animals can’t tell us how they are feeling,” she says. “It’s up to us to be proactive and do everything we can to make sure they live great lives free of pain and discomfort.”





“Animals can't tell us how they are feeling, so it's up to us to be proactive and do everything we can to make sure they live great lives free of pain and discomfort."
— Dr. Ann Duncan, associate vice president of life sciences for the Detroit Zoo
For questions or to donate appreciated assets, contact Kayne Karnbach at kkarnbach@dzs.org or (248) 336-5754.

By Kayne Karnbach, Manager of Individual Philanthropy
Donating appreciated assets — such as appreciated stocks and mutual funds — is a powerful and tax-efficient way to make a meaningful impact at the Detroit Zoo and Belle Isle Nature Center.
Appreciated assets often carry capital gains, which would be subject to taxation if sold. However, when donated directly to a 501(c)(3) nonprofit, you can avoid
capital gains tax allowing the full value of the asset to benefit the charitable organization.
In addition to bypassing capital gains tax, you may also receive a charitable income tax deduction for the fair market value of the asset at the time of the donation.
Shares from publicly traded stocks that have appreciated in value are donated
directly to the Detroit Zoological Society, allowing you to avoid capital gains tax and claim a charitable deduction for the full market value.
Ultimately, donating appreciated assets is a win-win: you achieve greater tax efficiency, and the Detroit Zoological Society receives a high-value gift that furthers our mission. It’s a thoughtful, strategic way to give that reflects both generosity and financial savvy.

Who looks after the animals who don’t live at the Detroit Zoo? At the Belle Isle Nature Center — also operated by the Detroit Zoological Society — that responsibility falls to two dedicated zookeepers, Marilynn Crowley and Jacob Van Keuren.
Their days are spent caring for the animals who call the Nature Center home — Michigan-native species such as turtles, snakes, frogs and toads. From cleaning habitats and monitoring health to making sure each animal has exactly what they need to thrive, their work is hands-on, detailed and full of heart.
“Being a zookeeper can be quite challenging sometimes, but it is also very rewarding. I have wanted to work closely with animals for my entire life so there isn’t much else I would rather do,” says Crowley. “One of the best things about working at the Nature Center is that you are surrounded by wildlife and these beautiful natural environments every day. Having so much local wildlife here on the

Island inspires you to advocate for the animals here in the Nature Center and all around you, especially in urban areas like southeast Michigan.”
Together, they care for more than 50 animals — all named after famous Michigan musicians, like Aretha Franklin and Stevie Wonder — and know each one’s quirks by heart. They know who prefers to be handfed, who enjoys a little extra attention and who would rather keep to themselves.
“Some animals are a little shy, and some are a little sassy,” Crowley says. “We work hard to get to know them as individuals and to create positive experiences, especially during things like medical checkups. We want them to associate us with good things so we can provide the best care possible.”
While the Nature Center team tries not to play favorites, Van Keuren admits a soft spot for the mudpuppies — an aquatic salamander species that lives right in the Detroit River. “They’re really unique,” he says.
From gray tree frogs to black rat snakes, each animal who calls the Nature Center home tells an important story about urban nature. Caring for them, Crowley and Van Keuren say, is deeply rewarding.
“I really enjoy talking with guests about reptiles and amphibians,” Van Keuren says. “They sometimes get overlooked, but they can be found right in your own backyard and are really important to conservation.”

Looking for a way to start the new year with purpose? Make a resolution that makes a difference — volunteer at the Detroit Zoo or Belle Isle Nature Center! You’ll spend time surrounded by incredible animals while supporting our mission to create meaningful connections between people, animals and the natural world so all can thrive. Still need a reason? Here are five more:

Research shows that giving back and spending time outdoors boosts both physical and mental health. With 125 acres of natural spaces at the Zoo and 5 acres at the Nature Center, this is the perfect place to relax, recharge and make an impact.
Weekdays, weekends or onetime events — we offer flexible shifts so volunteering works for you. When you open your brand-new 2026 calendar, you’ll see how easy it is to fit the Zoo into even the wildest of schedules.
This spring, Fred and Barbara Erb Discovery Trails opens at the Detroit Zoo — a 7-acre experience filled with handson adventures and up-close encounters. Be among the first to explore it all by volunteering in this brand-new space.
Last year alone, 2,292 volunteers contributed more than 60,933 hours at the Zoo and Nature Center. That adds up to a remarkable impact for our community, the animals and wildlife around the globe. Join us in 2026 and help ignite positive change!
Zoo and Nature Center volunteers meet new people, discover amazing animals and create memories that last a lifetime.




Can you find what’s hidden in plain sight? That’s the question posed by the newest art exhibition at the Detroit Zoo.
Camouflage is now open through Feb. 15 inside the Ford Education Center’s second-floor gallery. This temporary art exhibit features art quilts that celebrate the wonder of wildlife and the artistry of concealment. Guests will discover how talented fabric artists from across the country bring the fascinating survival strategies of animals to life. Through vibrant patterns, textures and colors, each piece reveals a story of adaptation, survival and self-expression.
“This exhibition is a chance to really take a closer look at nature and all the incredible ways wildlife is hidden around
“ This exhibition is a chance to really take a closer look at nature and all the incredible ways wildlife is hidden around us.”
— Ashley Ciricola, curator of fine and performing arts for the Detroit Zoo
us,” says Ashley Ciricola, curator of fine and performing arts for the Detroit Zoo. “Each piece in this temporary exhibit is truly incredible, one of a kind and a great representation of fiber arts. There’s something here for everyone to enjoy — nature lovers and art lovers alike.”
Hands-on interactives are woven throughout
the exhibition, including a community art piece where guests will select a strip of colored fabric and tie it onto a large grid panel. As the exhibit continues, the design will shift and change based on community involvement. As with many wildlife conservation efforts, one small action (like tying a piece of fabric) can have a meaningful impact when combined with the small actions of those around us.
“I love creating spaces in the Zoo where art comes alive and ties perfectly in with our mission to create meaningful connections between people, animals and the natural world so all can thrive,” Ciricola says.
The Camouflage art exhibition was created by the Studio Art Quilt Associates.






It’s officially giving season — and the Detroit Zoo is your one-stop shop for gifts that are anything but ordinary! From memberships that unlock year-round adventures to wild souvenirs that roar with personality, you’ll find something special for every animal lover on your list (and maybe a little something for yourself, too!). Shop your favorites in person at the Detroit Zoo Shop or online at shopdetroitzoo.com
Need a little inspiration? Explore our holiday gift guide to discover some wildly wonderful gifts we’re loving this season!



From $26.99
$21.99
$21.98







Butterflies can taste with their feet — how cool is that?
Butterflies can see secret colors we can’t — like ultraviolet light!
Escape the cold at the Detroit Zoo’s Butterfly Garden — a warm, colorful place filled with hundreds of fluttering butterflies! Turn winter into a tropical adventure and explore fun, kid-friendly activities to learn more about these amazing insects.
Learn more about insects at the Zoo!
Even in winter, bugs are all around — you just have to look closely! Some are camouflage pros, blending in with leaves, bark, or even snow. Try spotting hidden insects outside or visit the Zoo’s Butterfly Garden to see nature’s best hiders in action. Then, make your own sneaky bug!
You’ll need:
• Art supplies or found materials
• A friend or family member to help
What to do:
1. Pick a spot inside or outside to be your bug’s home (its habitat).
2. Look around — what colors and patterns do you see?
3. Choose your bug’s hiding style:
Blend in — match the colors of your space
Pattern power — use stripes or spots to confuse the eye
Disguise — make your bug look like something else (a leaf or rock!)
Mimic — design a bug that looks scary or dangerous to trick predators
4. Build your bug using materials from home.
5. Hide it and see how long it takes someone to spot it!
1. How many kinds of butterflies live at the Detroit Zoo?
A. 5
B. 25
C. 100
D. 250
2. Which butterfly hides bright blue wings under brown ones to blend in?
A. Glass wing
B. Monarch
C. Blue morpho
D. Peacock
3. Which butterflies can you find right here in Michigan?
A. Black swallowtail
B. Viceroy
C. Cabbage white
D. All of the above
4. The Painted Lady has traveled the farthest of all butterflies! How long was their trip?
A. 9,000 miles
B. 5,000 miles
C. 1,000 miles
D. 500 miles
Did you know butterflies actually have four wings, not two?

The Detroit Zoological Society family is deeply saddened to share the passing of Melissa Nagel, a beloved longtime guest relations supervisor.
Nagel, 70, passed away in July 2025. For more than a decade, Melissa was a cherished member of the Zoo community. Her warmth, dedication and kindness left a lasting impact on everyone she met — from her fellow staff members to the countless guests she interacted with and the animals she cared for deeply.
“Melissa was often one of the first people you’d see when arriving at the Zoo, greeting guests and staff with her warm smile and upbeat personality as soon as you walked through the front gates,” says CEO and Executive Director Dr. Hayley Murphy. “Whenever she was at work, she went above and beyond her duties – serving as a source of guidance, mentorship and a dear friend to many other staff members.”
Outside of her work at the Zoo, Nagel carried her love for animals into every part
of her life. She lived on a farm surrounded by animals — from horses, goats and chickens to cats and her beloved Italian greyhounds. Her compassion for animals truly knew no bounds. Nagel was a longtime fancier and board member of the Italian Greyhound Club of America and previously shared her passion for horses as a riding instructor with the Girl Scouts of Southeast Michigan.
Her creativity and curiosity extended beyond the animal world as well. A lifelong lover of the arts, Nagel earned a bachelor’s degree in art history and a master’s degree in art from Wayne State University.
To those who knew her well, Nagel was a light, whose smile and compassion truly made a difference.
“She brought joy into so many people’s lives, and her genuine passion for people was evident every single day,” Murphy says. “Her genuine gentleness and unwavering kindness will be truly missed.”



The Detroit Zoo is proud to partner with Polar Bears International (PBI) in tackling the biggest threats to the future of polar bears — climate change, pollution and human–polar bear conflict.
As part of PBI’s Arctic Ambassador Center Network, we join leading zoos, aquariums and wildlife parks in championing research, education and action. Through the Climate Alliance Program, we work on policy solutions and public engage-
ment that can ignite positive change on a global scale. At home in Detroit, the Zoo plays a unique role by studying what can’t be learned in the wild alone. Decades of close observation have revealed vital insights into cub development, maternal care and denning behavior — knowledge that fuels conservation strategies across the Arctic. With guidance from the Polar Bear Research Council, our work continues to build the science needed to secure a future for polar bears everywhere.















